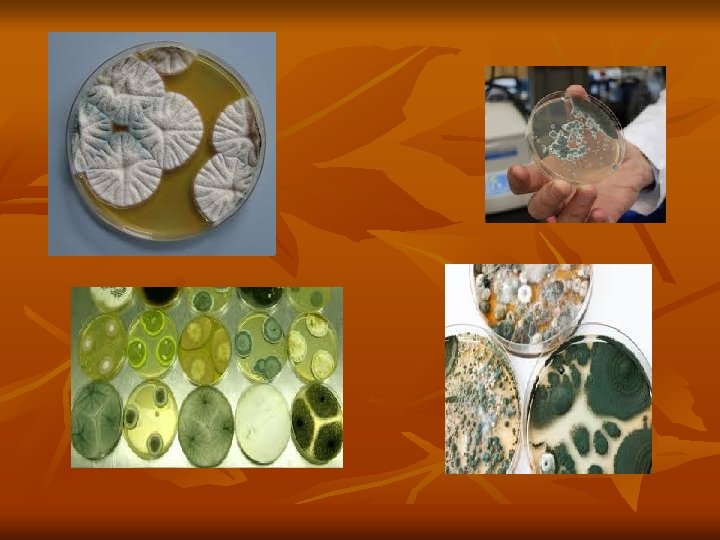

There are five kingdoms of living organisms Kingdom

![A fungus (/ˈfʌŋɡəs/; plural: fungi[3] or funguses[4]) n is a member of a large A fungus (/ˈfʌŋɡəs/; plural: fungi[3] or funguses[4]) n is a member of a large](https://slidetodoc.com/presentation_image_h/efa202e16560dcf50df01b105409422b/image-2.jpg)

- Slides: 17
There are five kingdoms of living organisms. Kingdom Characteristic Eample 1 - Monera Prokaryotic Bacteria Actinomycetes 2 -Protista 3 -Fungi 4 -Plantae 5 -Animalia Eukaryotic Protozoa Fungi Plants, Algae Arthropods Mammals Man
A fungus (/ˈfʌŋɡəs/; plural: fungi[3] or funguses[4]) n is a member of a large group of eukaryotic organisms that includes microorganisms such as yeasts and molds (British English: moulds), as well as the more familiar mushrooms. These organisms are classified as a kingdom, Fungi, which is separate from plants, animals, protists and bacteria. One major difference is that fungal cells have cell walls that contain chitin, unlike the cell walls of plants and some protists, which contain cellulose, and unlike the cell walls of bacteria. The fungi are in the Kingdom Fungi. *Eukaryotic organisms : - have nuclear membrane n surrounding nucleus Prokaryotic organisms : -nucleus lack nuclear n membrane
Both the plant and fungus kingdoms have some common characteristics. First, they are both eukaryotic, meaning they belong to the Eukarya domain and that their cells contain a nucleus and membrane-bound organelles. Both of them also have cell walls, are stationary, and are typically multicellular, which means they are made of multiple cells. Plants and fungi used to be grouped together but are no longer because of distinctive differences between these two groups. n
Plants, such as trees, flowers, and ferns, are n eukaryotic, non-motile organisms that use photosynthesis to get energy. Remember that photosynthesis is a process that converts sunlight and carbon dioxide into oxygen and sugar. While both plants and fungi have cell walls, the cell walls in plants are made of cellulose. Fungus, such as mushrooms, yeast, and mold, are eukaryotic, nonmotile organisms that are heterotrophic, which means that they must take in nutrients for energy. They have cell walls made of chitin. We can see these differences highlighted in the comparison here. While both are eukaryotic and don't move, plants are autotrophic - making their own energy - and have cell walls made of cellulose, but fungi are heterotrophic - taking in food for energy - and have cell walls made of chitin.
Evolution Of Fungus n Fungi, while they were once grouped with n plants, are actually more genetically similar to animals than plants. There are more than 1. 5 million different species of fungi ranging in size, function, and location. Much like plants evolved from plant-like protists, fungi evolved from fungus-like protists. As fungi have continued to evolve, they have become complex than their protist ancestors. Let's look at a few key steps in the evolution of fungus more
Mycology is the branch of biology concerned with the study of fungi which includes yeast and molds. Myco= derived from Greek word and -logy= study mykes is mean Mushroom fungi singular fungus a group of eukaryotic , n no phototrophic organisms with rigid cell walls , that includes molds , yeast and mushroom. Molds represent the basic structure of all n fungi: a weblike network of microscopic strands called mycelium (a hypha (plural hyphae) is a long, branching filamentous structure of a fungus ). n
Mushrooms : - are probably the best known n fungi. Usually found springing up on dead wood after cool, wet weather, the mushroom is a common sight. Mushrooms generally consist of a stalk with a large cap on top. This cap produces the spores that the mushroom releases in order to reproduce and colonize new environments. Many species of mushrooms are edible and delicious, but others can be very toxic.
Yeasts : - are non-filamentous, unicellular n fungi that are oval or spherical in shape. To a microbiologist, yeasts are the most important fungi, so I'll spend a little more time here. Yeast is the common term for any unicellular fungus. The mushrooms and molds are all multicellular organisms, but yeasts usually exist as only a single cell. The cell is larger than a bacterial cell and contains a nucleus and other organelles. Yeasts reproduce by budding
Fungi and the History of Mycology n Fungi, broadly defined, n (1) are eukaryotic, n (2) have no plastids or photosynthetic pigments, n (3) heterotrophic (unable to make their own food from n inorganic components), (4) Absorptive nutrition (digest food first then absorb by Releasing digestive enzymes to break down organic material or their host ). (5) Almost live as molds , mushroom (multicellular ) or n unicellular like yeasts (6) Almost all reproduce by sexual and asexual spores, n (7) Generally have haploid somatic nuclei (1 N) n (8) Lack true roots n n
The Importance of Fungi n Fungi are one of the most important groups of organisms on n the planet. This is easy to overlook, given their largely hidden, unseen actions and growth. A- Beneficial Effects of Fungi: n 1. Important decomposers & recyclers of nutrients in the n environment 2. industrial production of alcohols, fats, citric, oxalic and n gluconic acids. 3. Important sources of antibiotics, such as Penicillin. n 4. Model organisms for biochemical and genetic studies. n 5. Yeasts are used to make beer & bread n 6. Mushrooms eaten as food n 7. Help form blue cheeses n
B- Harmful Effects of Fungi: n 1. Destruction of food, lumber, paper, and cloth. n 2. Animal and human diseases, including allergies. n 3. Toxins produced by poisonous mushrooms or n within food 4. Plant diseases. n 5. Spoilage of agriculture products such as vegetables and cereals 6. Damage the products such as magnetic tapes and n disks, glass lenses, bones and wax. n
n